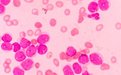
FDA批准安斯泰来AML药物Gilteritinib优先审评资格

两个来自美国和意大利的研究团队分别提出了避免CAR T细胞疗法治疗白血病患者过程中出现细胞因子风暴(CRS)的新方法。在第一项研究中,来自纽约纪念斯隆凯特琳癌症中心的研究人...
2018-05-31 09:30

FDA已经受理 brexanolone (SAGE-547)静脉注射液治疗产后抑郁的新药上市申请(NDA),并授予优先审评资格。
2018-05-31 09:22

根据《广东省人力资源和社会保障厅等八部门关于印发医疗机构药品交易“两票制”的实施方案(试行)的通知》(粤府〔2017〕32号),广东两票制方案自2017年12月2日实施,过渡期6...
文/山东风轻 2018-05-30 17:27

文/未晞 2018-05-30 15:10
5月29日,日本安斯泰来制药公布称,美国FDA已经接受了Gilteritinib用于有FLT3突变的复发或难治性急性髓细胞白血病(AML)成人患者治疗的新药上市申请(NDA),并给予其优先审评认定。
文/David 2018-05-30 13:36